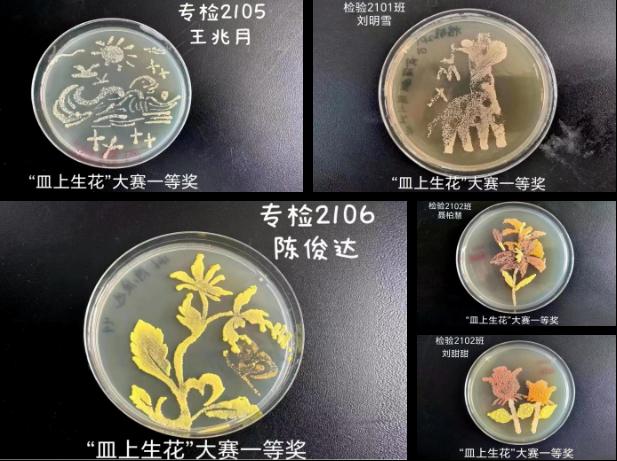
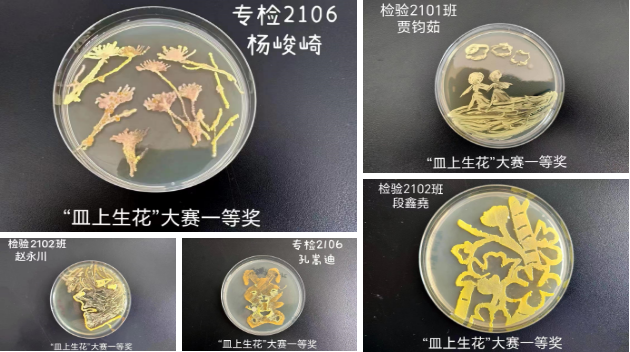

为了增加微生物学检验学习的趣味性,加深学生对微生物特性的进一步理解,提高微生物实验操作技能,培养同学们创造力和创新思维,养成“专心、细心和耐心”的工作作风,营造良好的校园文化氛围,检验系微免教研室《微检》教学团队举办“皿上生花”微生物培养皿艺术大赛。
本次大赛历时一个月,共有200余名学生参赛,学生利用课余时间,在30天内完成选菌、设计、绘画和细菌培养,作品完成后随时上交,由老师拍照留存。本次大赛学生参赛热情高涨,作品完成质量好。最终根据作品完成的难易度和整体效果评出一、二、三等奖。

一等奖作品展示
本次技能竞赛对提高学生学习微生物的兴趣,规范微生物基本实验操作、提升实验技能、激发学生探索生命奥秘的兴趣均具有较大的促进作用。同时,也为检验系实施实验教学改革、提高实验教学质量积累了经验。
撰稿:李媛媛
审核:关静岩
医学检验系微免教研室
2023年5月10日